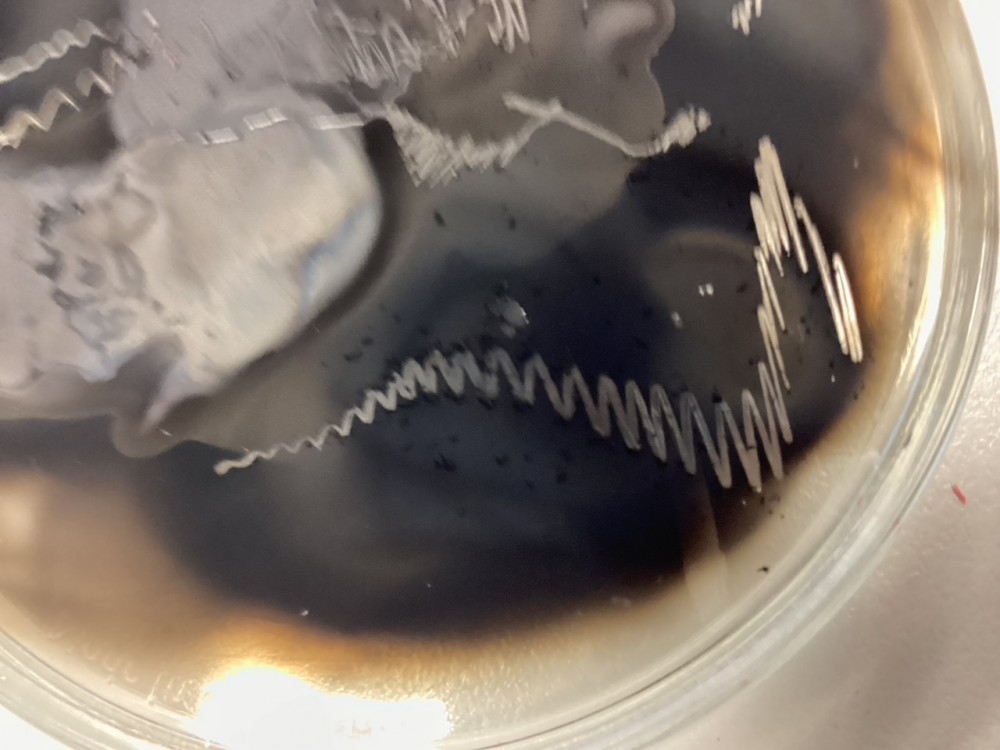

Die NawiPLUS-Klasse
Experimentierst du gerne?
Willst du den Dingen ganz genau auf den Grund gehen und herausfinden, warum Dinge so funktionieren, wie du es beobachtest?
Tüftelst du gerne an technischen Geräten herum?
Dann bist du bei uns in der NawiPLUS-Klasse genau richtig. In dieser Klasse kommen junge Forscherinnen und Forscher zum Zuge, die sich gerne mit naturwissenschaftlichen Phänomenen beschäftigen und experimentell Lösungen für Probleme entwickeln wollen.
Die NawiPLUS Klasse hat alle zwei Wochen nachmittags eine Extra-Doppelstunde im Fach Naturwissenschaften, die ganz dem praktischen Arbeiten gewidmet ist. Von Anfang an lernen wir, wie man an naturwissenschaftliche Fragen herangeht, Experimente plant und diese anschließend umsetzt und interpretiert.
So konstruieren und bauen wir z.B. ein Raketenauto und benutzen technische Geräte wie die Wärmebildkamera aus dem Klimakoffer unserer Schule.
Wir unternehmen auch Exkursionen, z.B. zum Regionalwettbewerb von Jugend forscht nach Koblenz, und nehmen an Wettbewerben wie Explore Science und Schüler experimentieren teil.
Durch die Zusammenarbeit in Teams lernst du, in kleinen Projekten intensiv und effektiv mit anderen Kindern zusammenarbeiten und deine Arbeitsergebnisse gemeinsam mit ihnen zu dokumentieren und zu präsentieren. Du wirst sehen: Es macht einen Riesenspaß, die Ergebnisse eigener Forschungen vorzustellen und mit Experten zu diskutieren.
![]() |
![]() |
![]() |
![]() |
![]() |